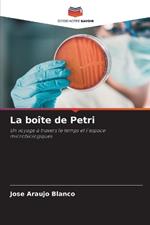

IBS.it, l'altro eCommerce
L’articolo è stato aggiunto alla lista dei desideri
Libri di Jose Araujo Blanco
Reparti
Offerte
Prezzo (€)
Autori
Editori e marche
Formato
Venditore
Tutti i risultati (5)
Die Petrischale
Venditore: IBS
Verlag Unser Wissen,
2024
Libri in Inglese | Science, Computer & Technology
Disponibilità in 2 settimane
101,80 €
A placa de Petri
Venditore: IBS
Edicoes Nosso Conhecimento,
2024
Libri in Inglese | Science, Computer & Technology
Disponibilità in 2 settimane
101,90 €
La bo?te de Petri
Venditore: IBS
Editions Notre Savoir,
2024
Libri in Inglese | Science, Computer & Technology
Disponibilità in 2 settimane
101,80 €
The Petri dish
Venditore: IBS
Our Knowledge Publishing,
2024
Libri in Inglese | Science, Computer & Technology
Disponibilità in 2 settimane
101,90 €
La Placa de Petri
Venditore: IBS
Editorial Academica Espanola,
2024
Libri in Inglese | Science, Computer & Technology
Disponibilità in 2 settimane
101,50 €
Informazioni sull’ordinamento
Vengono mostrati per primi i prodotti che rispondono a questi criteri: rilevanza rispetto alla ricerca, dati di venduto, disponibilità, data di pubblicazione, tipologia di prodotto, personalizzazione ad eccezione delle sponsorizzazioni.